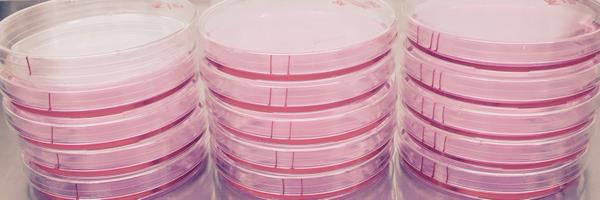
thebrookenapier Profile Banner

Brooke “Animalcules” Napier
@thebrookenapier
Followers
933
Following
3K
Media
259
Statuses
1K
Principal Scientist of Immunology @Seedhealth 🌱 PI of MIRA/NIGMS immunometabolism lab @Portland_State My thoughts and views are my own.
Portland, OR
Joined June 2009
Review: A new frontier for fat: dietary palmitic acid induces innate immune memory @SeufertAmy @thebrookenapier @ImmunoMet
https://t.co/TQ3FE2oWGw
0
3
6
More sisterly sciencey snow time with @RuthJeanNapier - who else can you talk to about T cell mediated inflammatory diseases on the chairlift?!?
1
0
11
I have stepped out into biotech - as a Principal Scientist at @seedhealth - it’s both exciting and scary, but our small and mighty R+D team has been unbelievably inspiring and it feels good to work on a probiotic that I truly believes hold immense power.
2
0
17
That time you find the largest, and most expensive, mausoleum in the cemetery in Buenos Aires - and it’s Nobel winner Luis Federico Leloir and you get to describe lactose metabolism to your buddy.
0
0
19
Thanks to @algejohn for flying all the way to the best coast to present his amazing work on primitive gasdermin pores and chatting with our faculty and students - badass science and a badass person! 🙌⚡️
0
1
10
Here's our press release on our new study finding ketogenic diet induces trained immunity:
pdx.edu
A new study by Portland State University researchers is the first to show that eating a diet exclusively high in saturated fats can reprogram the mouse immune system, making it better able to fight...
0
3
9
These women are the reason why I love @PSU_Biology - they are all incredible women who go above and beyond in their jobs, and I’m lucky to be around them @ber_pdx @Portland_State
1
1
14
Anyone who knows Robbie and I, knows we love to talk. Needless to say, we jumped at the opportunity to chat about our science and life as a science couple with Jason and Brenda at @ImmunoPodcast!
We have a new episode out! Drs. Kristin Patrick and Robert Watson (@The_PW_Lab) from @TAMU talk about #gasdermin D and cell death in #tuberculosis, and how running a lab together helps them prioritize mentorship. 🎧 Check it out: https://t.co/eoT9a3mHNt
1
1
16
Sometimes I feel like kid still, and sometimes I realize my lifelong best friend from grade school is on Bloomberg. Are we adults now?
I went on @BloombergTV and explained that speculation over whether a recession is coming should be secondary to whether we are prepared for one. At least when it comes to unemployment insurance, we certainly are not. Full show here https://t.co/9TV9nYkOQ7
1
1
9
I'm so excited to share the first paper from the Napier Lab showing that dietary saturated fatty acids induce trained immunity via reprogramming the bone marrow compartment and altering outcome of inflammatory disease & infection!
elifesciences.org
Enriched dietary SFAs, specifically palmitic acid (PA), induce a broad and long-lived innate immune memory response which is harmful during disease exacerbated by inflammation, but beneficial for...
6
10
59
40 miles in the Alaskan wilderness in the books! (The paper is still pending initial approval 💀👀) Now time to start an exciting new fall term! Looking forward to our new MS student Hugh joining us this term!
1
0
11
Heading to Alaska for my pre-fall-term / just-resubmitted-a-huge-manuscript backpacking trip!
0
0
18
Congrats to all of this years outstanding Hannah Gray fellows and their mentors!
0
1
7
Napier Lab Retreat 2022 - feat. climbing lessons and sunset paddle boarding!
0
0
11
Come to Portland to do Immunology!
🔥J O B opportunity in The City of Roses..Join @ohsummi as a Faculty member...great students, collaborations, outdoors, food & drink #WomeninScience #ScienceJobs 🐭🧬apply here: https://t.co/uwFSjCYi9m
0
1
3
Check out our epic complement receptor C3aR review on it’s role in controlling bacterial infection - there are a lot of twists and turns 🌪@pyroptosisguy
journals.plos.org
Activation of the complement pathway results in the production of bioactive C3a, a product of C3 cleavage, which interacts with membrane-bound receptor C3aR to regulate innate immune cell function...
2
3
15